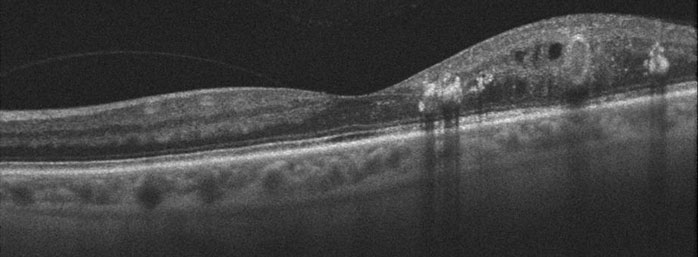

If you have been diagnosed with diabetes and are afraid of losing your vision, you are not alone. Diabetes has many faces—it affects people of all ages, races, and nationalities. Of the almost 40 million people in the United States with diabetes, almost half will eventually develop some sort of diabetic eye disease.
Diabetes primarily affects the blood vessels in the retina, the light sensing tissue at the back of the eye. These vessels work like hoses, bringing oxygen and other nutrients into and out of the eye. Damage to these vessels is called diabetic retinopathy. Diabetic retinopathy develops gradually and painlessly.
Although good control of your blood sugar and blood pressure can help prevent diabetic eye disease, significant problems can still occur. Regular dilated eye examinations are therefore the only way to diagnose problems early before vision loss occurs.
Diabetic vision loss is often preventable with early detection and treatment. At Bennett & Bloom Eye Centers, we specialize in all aspects of diabetic eye disease. The advanced diagnostic and treatment techniques we use often keep you seeing normally, allowing you to enjoy life to its fullest.
When we eat, food is broken down into sugars (glucose), fat (triglycerides) and proteins. Insulin, produced by the pancreas, drives glucose into the cells. Diabetes mellitus is a disease causing the blood glucose to become elevated by either a lack of insulin production by the pancreas (Type 1) or resistance of insulin to get glucose into our cells (Type 2). Type 1 diabetes is diagnosed early in life and patients require insulin injections in order normalize glucose levels. Type 2 diabetes occurs later in life and can be controlled with diet, pills, insulin, or other medications depending on its severity. Approximately 30 million Americans (1 out of every 9 people) have diabetes, with about 25% of those who are undiagnosed. An unbelievable 100 million Americans (almost 40%) have prediabetes, 15-30% of whom will develop diabetes within 5 years.

Diabetes primarily affects the blood vessels that nourish the retina. The retinal vessels work like a garden hose, bringing oxygen and other nutrients into and out of the eye. Diabetes causes them to sprout tiny leaks, or microaneurysms (non-proliferative diabetic retinopathy), which makes the surrounding retina swell and not work properly. Central vision can become blurred, just as a water droplet placed on a photograph will cause the picture to blister and become distorted (diabetic macular edema).
Diabetes can also make the blood vessels close off. Some eyes will develop tiny new blood vessels in an attempt to increase the retinal blood supply (proliferative diabetic retinopathy). These new vessels do not help the eye, however. They are fragile and can cause blindness by bleeding (vitreous hemorrhage) or causing a retinal detachment.

Diabetic macular edema
Proliferative diabetic retinopathy
Diabetic retinopathy develops gradually over many years. People with Type I diabetes, those requiring insulin to control their blood sugar, and patients with diabetes for many years are at an increased risk for developing retinal problems. Poor control of blood glucose, pregnancy, uncontrolled high blood pressure, and smoking also aggravate diabetic retinopathy.
Approximately 50% of diabetics will develop some form of diabetic retinopathy. Diabetic retinopathy is the leading cause of vision loss and new-onset blindness in the United States in those 20 to 74 years of age, with new cases of blindness developing in 12,000 to 24,000 persons annually. Remarkably, much of this vision loss is preventable with more timely diagnosis and treatment.
You can’t diagnose diabetic retinopathy by looking in the mirror since your eye will usually look and feel normal. Vision is also often normal despite the presence of potentially blinding eye conditions. Only a thorough retinal examination through a dilated pupil can detect these problems. Properly timed treatment can often stabilize vision although it is less likely to improve it. The key to maintaining good eyesight, therefore, is early diagnosis and treatment before symptoms occur. Most diabetic patients need a dilated eye examination at least once a year throughout their lifetime. Further testing, including photography, fluorescein angiography, and OCT scanning may be done to assist in the diagnosis and treatment of any changes thought to cause visual loss.


Laser photocoagulation is one of the main ways that diabetic retinopathy is treated. A laser is an instrument that produces a pure, high-intensity beam of light energy. The laser light can be focused onto the retina, selectively treating the desired area while leaving the surrounding tissues untouched. The absorbed energy heats, or photocoagulates, the retina, creating a microscopic spot. Laser surgery is performed in our office while you are awake and comfortable. The laser treatment usually takes less than 30 minutes to complete and you can go home immediately following surgery. Arrangements for transportation should be made in advance since you may not be able to drive right away. It will take several weeks to months before we can tell whether laser surgery has been successful. Since diabetes is a progressive disease, many patients need more than one treatment to control their eye problem and prevent further loss of vision.
The laser is used to seal the leaking vessels causing macular edema (focal or grid laser photocoagulation). Although photocoagulation decreases the risks of persistent macular edema and significant visual loss by about 50%, it does not significantly improve vision. It is therefore used primarily in eyes with non-central macular edema, and as supplemental treatment in eyes receiving intraocular injections.


New vessels in eyes with proliferative retinopathy can often be made to disappear with panretinal photocoagulation (PRP). Microscopic laser spots, placed into the peripheral retina, improve retinal circulation causing neovascularization to disappear. PRP is generally completed in 2-3 sessions over several weeks to months. It decreases the risk of severe vision loss by at least 50%, and often provides a lifelong fix for proliferative disease. However, some patients will still require additional treatments or vitrectomy surgery for vitreous hemorrhage or retinal detachment.



VEGF inhibitors (Avastin, Lucentis, and Eylea) and intraocular steroids strengthen leaking diabetic retinal vessels. Another drug, Vabysmo, inhibits both VEGF and Ang-2, another pathway responsible for new blood vessel growth. These agents have become the treatment of choice for central diabetic macular edema.
Avastin, Lucentis, Eylea and Vabysmo are equally effective with good baseline vision; for eyes with worse initial vision, Eylea or Vabysmo are often the first choice since they appear to more rapidly improve eyesight. Unlike laser photocoagulation, vision often improves significantly (1-2 lines) and about 30% of eyes gain ≥ 3 lines, although it can take many months and injections for maximal results. Laser photocoagulation can be used as a supplemental treatment to help decrease the number of intravitreal injections. The need for additional injections and lasers tends to decrease over time, requiring nearly monthly injections initially in most patients before tapering off to virtually zero after 5 years.
Intravitreal steroids (Kenalog, Triesence and Ozurdex) are a reasonable choice for initial therapy in eyes that have had cataract surgery and is associated with a much lower frequency of injections. Sustained release steroids (Ozurdex and Iluvien) are typically used as supplemental treatments. Kenalog is effective for up to six months, the sustained release dexamethasone (Ozurdex) is effective for 2-3 months) and the sustained-release fluocinolone (Iluvien) is effective for up to 3 years. Common steroid side-effects include elevated intraocular pressure and cataract. About 40% of eyes treated with steroids will need some form of pressure lowering therapy which can usually be managed with eye drops.
Some patients with severe proliferative retinopathy will develop extensive bleeding or retinal detachment that can cause blindness. Vitrectomy surgery is done in the operating room on an outpatient basis. These advanced microsurgical techniques often allow us to restore vision by removing the hemorrhage and bleeding tissues.

